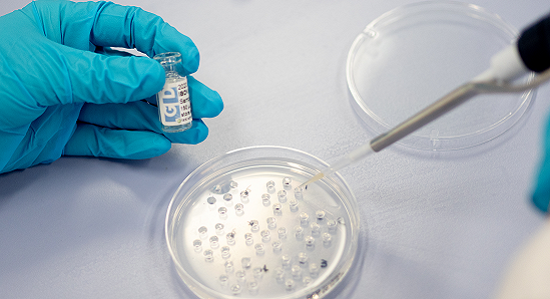

Products & services
Royal GD is a leading organisation in animal health and animal production. We support our customers worldwide, thanks to state-of-the-art veterinary laboratories and research facilities, and our veterinary knowledge and expertise. We can support your livestock business with animal health expertise, research and development, and diagnostics. This unique combination of strengths enables us to offer you laboratory tests and to help you interpret the results. We also offer a wide variety of animal health products and services.

Contract research
For many years, GD has been a partner within the animal health industry worldwide. In our facilities, we perform many in-vivo and in-vitro laboratory and field studies on biologicals and pharmaceuticals with full scientific support and quality control. The studies are conducted in accordance with international standards and requirements (e.g. EP monographs, OIE and VICH guidelines), national and international regulations and support the development, registration or marketing of veterinary products. Optionally, these studies can be performed to meet GMP, GLP and GCP standards. More about contract research
Our portfolio, but is not limited to:
- Safety and efficacy studies
- Studies to obtain vaccine or challenge-strain candidates
- Quality control tests of end products
- Development of animal models
- Surveys on the prevalance of (emerging) infectious diseases and agents
- Custom-made courses regarding animal health, management and laboratory techniques
- Test kit validation studies

Research & Development
The R&D department is responsible for development of new products and programmes. R&D is also involved in validation and quality assurance of diagnostic tests in our operational laboratory as well as in animal health surveillance programmes and contract research. Based on our expertise in the laboratory and from the field, we develop new products for our clients and try to further improve existing products. The department has its own R&D laboratory and a team of specialists focussing on epidemiology.
Epidemiology
Our epidemiology team assists and carries out the design, analysis and reporting of studies. The types of study range from clinical trials to large field studies. The epidemiologists have broad experience with big data sets and can apply all statistical techniques needed in the studies.

Veterinary laboratory tests
Royal GD operates one of the largest and most modern veterinary laboratories in the world. Its employees are international experts in the field of animal diseases. Our laboratory houses the following disciplines: pathology, histopathology, microbiology, virology, molecular biology, serology, chemistry and toxicology.
GD offers Animal Health Expertise, Research & Development and Diagnostics. This unique combination of strengths enables us to not only offer you laboratory results, but also to help you interpret the results in order to offer you a wide variety of animal health solutions.
ISO 17025
Modern equipment and robots enable us to carry out large-scale testing accurately, quickly and efficiently. Our laboratory meets the highest possible quality requirements and has been ISO 17025 accredited by the Dutch Accreditation Council (RvA) for a large number of laboratory tests (registration number L120 Testing).
GLP & GCP
We expect to perform contract research in compliance with GLP guidelines in 2017. We can perform contract research according to GCP guidelines.
FTA
An FTA card is a chemically treated filter paper designed for the
collection, preservation and shipment of biological samples
for subsequent DNA and RNA analysis. Special chemicals lyse
and inactivate bacteria and viruses and preserve their DNA and
RNA for detection by PCR.
Submitting samples on FTA cards is easy and fast and samples can be submitted to our laboratory from any country. The main benefits of using FTA cards are:
- no risk for spreading infectious agents due to the chemicals included;
- no import permit is needed;
- transportation at room temperature;
- submitting samples via regular post;
- low transportation costs.
Proficiency testing schemes (PTS)
Inter-laboratory study
Verify your quality with our proficiency testing schemes. Proficiency testing is an inter-laboratory study to determine the performance of individual laboratories for specific tests, and to monitor laboratories’ continuing performance. Taking part in a proficiency testing scheme is a valuable part of a laboratory’s quality control management.
Quality standards
GD is unique in having multidisciplinary state-of-the-art laboratories,
including R&D support, all on one site. Our laboratory has
130 employees and is supported by experts in chemistry, microbiology, virology,
veterinary medicine and veterinary pathology ensuring state-of-the-art techniques
and methods.
The GD has been ISO 17025 accredited by the Dutch
Accreditation Board (RvA) for a large number of laboratory tests (registration
number L120 Testing). GD has been accredited according to the ISO 17043:2010 for the organization of most of the proficiency testing schemes for antibody detection and molecular biology (registration number R016 Prof. Testing). This ensures our technical competence as your PTS provider. In addition, we are ISO 9001 certified, which means
that we work according to a quality-management system that meets the requirements
of the standard ISO 9001, and is continuously improving the organisation and its
processes in order to meet customer expectations and deliver customer satisfaction.
Diagnostics: biological reagents
GD offers a large number of antigens, monospecific antisera and reference sera, carefully selected to obtain optimum results in laboratory tests. The diagnostics are produced in our own facilities. Our well-defined sera are also used in our proficiency testing schemes. All antigens, antisera and reference sera are freeze dried to extend their shelf life and guarantee long-term stability.
Technical support
Our Research and Development (R&D) staff and laboratory technicians can answer your technical or practical questions concerning the use of diagnostics products and the associated techniques. You are welcome to consult them.
Our distributors
In Egypt, Iran, Thailand, Turkey, Azerbaijan, North-Cyprus, Pakistan our Diagnostics
are sold through our distributors. These distributors can give detailed information,
answer questions and offer help with orders. Are you interested in becoming a
distributor to provide customers with our products and services? Please send us an
email: support@gdanimalhealth.com.

GD Academy
Enhance your knowledge with GD Academy. We provide training programmes related to animal diseases for farm staff and their veterinarians, the veterinary pharmaceutical industry, the animal feed industry and the government. We also offer theoretical and practical courses on the implementation of veterinary diagnostic lab-test methods and the ISO17025 Quality System. Besides, we provide lectures and keynotes all over the world.
Our training programmes can be fully custom made in order to meet your needs. They may be given at GD, at another location in the Netherlands or abroad. We would love to hear your training requirements so we can create a course that fulfills your wishes. More information